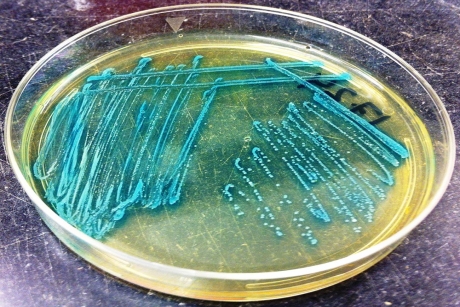
Produce safety enhanced by timing harvesting

Produce safety enhanced by timing harvesting
Listeria monocytogenes like moist, damp conditions, and rain or irrigation creates soil conditions that are more hospitable to the bacteria. Now new research has shown that if farmers put off harvesting for at least 24 hours following rain or irrigation, the likelihood of exposing consumers to the bacteria is reduced.
In Australia, the food-borne disease Listeriosis, which is caused by the ingestion of Listeria monocytogenes, is on the Communicable Diseases Network Australia (CDNA) list of communicable diseases so it is imperative that food processors do everything they can to protect consumers from exposure.
Factors such as proximity of a field location to water and other landscape features also play important roles in the presence of Listeria. Cornell scientists, along with other US agricultural researchers, tested fields in a variety of locations throughout New York and found that after rains or irrigation, the chances of finding Listeria were 25 times greater. But, after the fields dried at least 24 hours, the chances of detecting Listeria dropped dramatically, to levels similar to baseline. Their results have been published in the journal Applied and Environmental Microbiology.

“We’re looking at the science that helps governmental entities, such as the US Food and Drug Administration, and private entities create policies that keep our food supply safe,” said Daniel Weller, a doctoral student in the field of food science and the lead author of the new work, Spatial and Temporal Factors Associated With an Increased Prevalence of Listeria monocytogenes in New York State Spinach Fields. The other authors are Martin Wiedmann, Cornell’s Gellert Family Professor in Food Safety, and Laura Strawn, Ph.D. ’14, assistant professor at Virginia Tech.
Currently in the US, the FDA has proposed rules allowing farmers to apply “wait periods” after application of irrigation water. This would allow for “potentially dangerous microbes to die off”, said the FDA.
Through a combination of weather data, GIS technology and data-driven information, technology allows farmers and producers to take a systems approach managing food safety.
Said Wiedmann: “Current technology tools are improving food safety and increasing consumer confidence in food products.”
This research was funded by The Center for Produce Safety.
Argon & Co partners with QAD | Redzone
Management consultancy Argon & Co partners with QAD | Redzone workforce technology to help...
Are consumers ready for food made from seafood sidestreams?
A European survey says 74% have a positive or neutral attitude towards eating food made from...
Novel shock method for calculating coffee flavour
US scientists have developed a quick test that applies voltage to black coffee to determine its...












